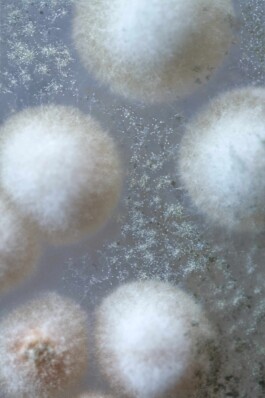

Send your application before 16 June 2026
Caring for children leaves traces. In the body, in time, in the way you work. Zorgsporen is a two-week residency at Kunstliefde in Utrecht, for artists with experience in full-time care for young children. A place without production pressure — for experiment, exchange, and deepening of your practice.
Zorgsporen is a collaboration between Kunstliefde and the Dutch branch of M.A.R.S.
Period: 25 August – 13 September 2026
Send your application before 16 June 2026
Caring for children leaves traces. In the body, in time, in the way you work. Zorgsporen is a two-week residency at Kunstliefde in Utrecht, for artists with experience in full-time care for young children. A place without production pressure — for experiment, exchange, and deepening of your practice.
Zorgsporen is a collaboration between Kunstliefde and the Dutch branch of M.A.R.S.
Period: 25 August – 13 September 2026
Vernissage 29.05. 18.30
Research-based exhibition reclaiming female monsters as queer-feminist figures of resistance, abjection and care, situated in dialogue with sex work and local histories
VERNISSAGE : 18.30
A project by Hannah Kindler
Vernissage 29.05. 18.30
Research-based exhibition reclaiming female monsters as queer-feminist figures of resistance, abjection and care, situated in dialogue with sex work and local histories
VERNISSAGE : 18.30
A project by Hannah Kindler
Buy Art, Support M.A.R.S.
MARS runs the Orbit Gallery, a producer-run gallery that represents the work of its members and creates fair conditions for artistic production.
The gallery is not a commercial sales platform, but a solidarity-based infrastructure. It provides visibility, exchange, and fair participation in shared resources.
When you purchase an artwork through the Orbit Gallery, you support both the artist and the collective.
Between 80–85 % of each sale goes directly to the artist, while the remaining 15–20 % sustains MARS’ shared structures such as care, communication, publishing, collective projects, artistic research, and administrative work. This ensures that every purchase contributes to the ecosystems that make these practices possible.
Each sale is handled transparently: prices are agreed together with the artists, and buyers can receive information about provenance, technique, and edition upon request.
Artworks can be purchased either through the Orbit Gallery or directly from the artists.
For direct sales, we encourage a voluntary solidarity contribution to the collective – a gesture that sustains the shared infrastructures making this work possible.
In this way, an economy of connection emerges – one that links artistic production, care, and collective responsibility rather than competition.
DONNATIONS
M.A.R.S. – Maternal Artistic Research Studio e.V. is a registered non-profit association dedicated to supporting artists, researchers and cultural practitioners who integrate care into their work.
Donations directly fund artist fees, new productions, publications and collective gatherings. They help us create fair conditions for artists with care responsibilities and sustain infrastructures of artistic and social collaboration.
Every contribution, small or large, strengthens the M.A.R.S. movement and keeps its projects accessible.
As a non-profit organisation, all funds are used exclusively for artistic and cultural purposes. Donation receipts can be issued upon request.
OFFER PRACTICAL Support
You can also support M.A.R.S. by sharing your time, space or skills. This could include offering a studio or exhibition venue, childcare, transport or accommodation for artists, translation or documentation support, help with design, writing, editing or communication, access to printing or production facilities, or professional expertise in organisation, finances, or law.
It can also mean sharing visibility: inviting us into networks, connecting us with potential collaborators, or helping our projects reach new audiences.
These forms of support are vital for maintaining accessibility and care within M.A.R.S.; they allow those who might otherwise be excluded to participate fully, to show their work and to continue their artistic and care practices under fairer conditions.
Every contribution of time, space or expertise is deeply appreciated.
Together we sustain a structure in which artistic work and care work can coexist and support one another.
Corporate Sponsorship
Corporate Membership
Corporate Members are long-term allies who help sustain the infrastructures that make M.A.R.S. possible.
Through annual contributions, companies support artists, publications and workshops that connect art, care and community in meaningful ways.
Corporate Membership is an opportunity to engage with an international network of artists and thinkers, while fostering a culture of care and creativity within your organisation.
Corporate Members receive:
– Official listing on the M.A.R.S. website and printed materials
– Invitations for two representatives to previews and gatherings
– Early access to editions and publications
– Annual Behind the Scenes insight session with artists and curators
– Option to co-host a M.A.R.S. salon, dinner or creative workshop for staff or clients
– Tailor-made consulting on care & creativity (on request)
Suggested contribution: from €5,000 per year
Corporate Sponsorship
For companies wishing to contribute on a flexible or project-based basis — supporting exhibitions, performances, publications or annual programs.
Sponsorships can be one-time or renewed annually as part of an ongoing partnership.
Each collaboration is tailored individually to ensure that your company’s engagement aligns with its values and guiding principles.
Sponsorships may include:
– Exclusive previews or guided tours
– Private artist talks or studio visits
– Commissioned artworks or editions
– Logo presence on selected materials and publications
– Invitations to M.A.R.S. partner events
Tiers:
Sponsorships start from €2,500 for a Project Sponsor, from €5,000 for a Main Sponsor, and from €10,000 for a Lead Partnership.
All sponsorships directly fund artists, research and public programs that sustain the M.A.R.S. movement.
BECOME A MEMBER OF M.A.R.S.
Member of M.A.R.S. Collective
This membership is for cultural producers such as artists, performers, curators, writers and researchers who wish to actively engage with the M.A.R.S. collective.
This membership grows from a mutual collaboration. You can reach out and propose a project, join a workshop, co-create a publication or join one of our collaborations.
Once a collaboration has taken place and mutual interest is expressed, a formal membership of the collective is decided collectively by the group.
Benefits
– Participation in collective projects, residencies and workshops
– Visibility on our website and in M.A.R.S. publications
– Voting rights in association assemblies
– Invitations to member meetings and community gatherings
– Eligibility to propose new collaborative formats or host events under the M.A.R.S. framework
Annual contribution: 25 € (reduced fee available on self-assessment basis)
BECOME A MEMBER OF M.A.R.S.
Member of M.A.R.S. Collective
This membership is for cultural producers such as artists, performers, curators, writers and researchers who wish to actively engage with the M.A.R.S. collective.
This membership grows from a mutual collaboration. You can reach out and propose a project, join a workshop, co-create a publication or join one of our collaborations.
Once a collaboration has taken place and mutual interest is expressed, a formal membership of the collective is decided collectively by the group.
Benefits
– Participation in collective projects, residencies and workshops
– Visibility on our website and in M.A.R.S. publications
– Voting rights in association assemblies
– Invitations to member meetings and community gatherings
– Eligibility to propose new collaborative formats or host events under the M.A.R.S. framework
Annual contribution: 25 € (reduced fee available on self-assessment basis)
Supporting Membership
Supporting Membership
Supporting Members help M.A.R.S. maintain the structures that make artistic and care work possible. Your contribution supports artist fees, new projects, publications and public gatherings. By becoming a regular supporter, you help build a space where care and artistic labour are valued and sustained. As a Supporting Member, you become part of a growing community that believes in fair conditions for artists and in art as a shared responsibility.
Choose the membership level that fits your situation:
Seed Member – 25 € / year
For students, artists, activists and other allies who wish to join in solidarity at an accessible rate. A seed contribution that helps new ideas grow and connects you to the M.A.R.S. community.
Thank you gift:
Support Member – 60 € / year
For engaged supporters who wish to help the movement grow through steady support sustaining projects, artists and shared spaces of care. Your contribution helps M.A.R.S. remain active, visible and fair.
Thank you gift:
Circle Member – 150 € / year
For those who want to take an active role in sustaining M.A.R.S., staying close to its projects, sharing its values and contributing to the collective’s ongoing work. Circle Members help maintain the connections that keep the movement dynamic and evolving.
Thank you gift:
Care Patron – 500 € / year
For individuals, collectors, foundations or organisations who wish to take a special role in supporting M.A.R.S. Care Patrons make ambitious projects possible and strengthen the long-term sustainability of the movement. Their commitment helps secure fair conditions for artists and expand the shared infrastructures of art and care.
Thank you gift:
Supporting Membership
Supporting Membership
Supporting Members help M.A.R.S. maintain the structures that make artistic and care work possible. Your contribution supports artist fees, new projects, publications and public gatherings. By becoming a regular supporter, you help build a space where care and artistic labour are valued and sustained. As a Supporting Member, you become part of a growing community that believes in fair conditions for artists and in art as a shared responsibility.
Choose the membership level that fits your situation:
Seed Member – 25 € / year
For students, artists, activists and other allies who wish to join in solidarity at an accessible rate. A seed contribution that helps new ideas grow and connects you to the M.A.R.S. community.
Thank you gift:
Support Member – 60 € / year
For engaged supporters who wish to help the movement grow through steady support sustaining projects, artists and shared spaces of care. Your contribution helps M.A.R.S. remain active, visible and fair.
Thank you gift:
Circle Member – 150 € / year
For those who want to take an active role in sustaining M.A.R.S., staying close to its projects, sharing its values and contributing to the collective’s ongoing work. Circle Members help maintain the connections that keep the movement dynamic and evolving.
Thank you gift:
Care Patron – 500 € / year
For individuals, collectors, foundations or organisations who wish to take a special role in supporting M.A.R.S. Care Patrons make ambitious projects possible and strengthen the long-term sustainability of the movement. Their commitment helps secure fair conditions for artists and expand the shared infrastructures of art and care.
Thank you gift:
UPCOMING AND CURRENT EVENTS
Send your application before 16 June 2026
Caring for children leaves traces. In the body, in time, in the way you work. Zorgsporen is a two-week residency at Kunstliefde in Utrecht, for artists with experience in full-time care for young children. A place without production pressure — for experiment, exchange, and deepening of your practice.
Zorgsporen is a collaboration between Kunstliefde and the Dutch branch of M.A.R.S.
Period: 25 August – 13 September 2026
Send your application before 16 June 2026
Caring for children leaves traces. In the body, in time, in the way you work. Zorgsporen is a two-week residency at Kunstliefde in Utrecht, for artists with experience in full-time care for young children. A place without production pressure — for experiment, exchange, and deepening of your practice.
Zorgsporen is a collaboration between Kunstliefde and the Dutch branch of M.A.R.S.
Period: 25 August – 13 September 2026
Vernissage 29.05. 18.30
Research-based exhibition reclaiming female monsters as queer-feminist figures of resistance, abjection and care, situated in dialogue with sex work and local histories
VERNISSAGE : 18.30
A project by Hannah Kindler
Vernissage 29.05. 18.30
Research-based exhibition reclaiming female monsters as queer-feminist figures of resistance, abjection and care, situated in dialogue with sex work and local histories
VERNISSAGE : 18.30
A project by Hannah Kindler
PAST EVENTS
Starting from reborn dolls—hyper-realistic replicas of infants that are played with by women online—Winnie Luzie Burz performs a hybrid of puppet theatre, reenactment, and livestreaming, unfolding across both an analogue and a digital stage.
A project by Winnie Luzie Burz
Exhibition, Performance, Artist Talk, Film Screening, Workshops, Symposium
06.03. 18.00 OPENING AND PERFORMANCE 12.03. 17.00 CLOSING AND SYMPOSIUM
Participatory needlework gathering inviting fathers, brothers & allies to rethink care, parenthood & responsibility.
1000 vases circulate from collective mass to individual use, foregrounding participation, care and urban commons.
A project by Hannah Kindler & Milena Naef
Participatory two-hour workshop on the occasion of International Women’s Day focussing on how women* have empowered and made each other visible throughout history.
A project by Hannah Kindler, Katarina Strasser and Katharina Wenk
Participatory two-hour workshop on the occasion of International Women’s Day focussing on how women* have empowered and made each other visible throughout history.
A project by Hannah Kindler, Katarina Strasser and Katharina Wenk
The exhibition featuring a selection of new works on paper and several site-specific interventions.
A project by Mirjam Walter
Talk on textile-based practice, care, motherhood & first printmaking experiments.
Participatory needlework gathering inviting fathers, brothers & allies to rethink care, parenthood & responsibility.
A project by Sanne Freitag
The exhibition centers on Drag *KINGS*. With humor, political intent, and a bold touch of glamour (and punk), artists from Bielefeld, Münster, and beyond take the stage.”
Vernissage: 12.09.25 18.00
A project by Katharina Bosse